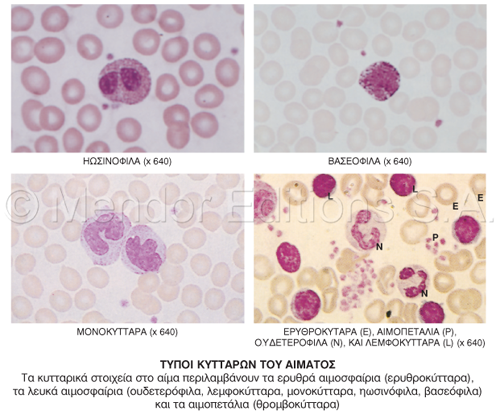

Αγγλικός όρος
blood
Ορισμός
Υγρό που κυκλοφορεί διαμέσου της καρδιάς, των αρτηριών, των φλεβών και των τριχοειδών αγγείων, μεταφέροντας θρεπτικά υλικά,
ηλεκτρολύτες, ορμόνες, βιταμίνες, αντισώματα, θερμότητα και οξυγόνο στους ιστούς και απομακρύνοντας άχρηστα υλικά και διοξείδιο του άνθρακα.
ΧΑΡΑΚΤΗΡΙΣΤΙΚΑ: Το αίμα έχει χαρακτηριστική και κατά κάποιο τρόπο μεταλλική οσμή. Το αρτηριακό αίμα είναι ανοικτό ή βαθύ κόκκινο και συνήθως
αναβλύζει, όταν ραγεί η αρτηρία. Το φλεβικό αίμα είναι σκούρο κόκκινο και ρέει σταθερά από μια ραγείσα φλέβα.
ΣΥΣΤΑΣΗ: Το ανθρώπινο αίμα
αποτελείται περίπου κατά 52%-62% από πλάσμα και κατά 38%-48% από κύτταρα. Το πλάσμα αποτελείται κυρίως από νερό, ιόντα, πρωτεΐνες, ορμόνες και
λιπίδια. Τα κυτταρικά στοιχεία αποτελούνται από τα ερυθροκύτταρα (ερυθρά αιμοσφαίρια), τα λευκοκύτταρα (λευκά αιμοσφαίρια) και τα θρομβοκύτταρα
(αιμοπετάλια). Τα λευκοκύτταρα αποτελούνται από ουδετερόφιλα, ηωσινόφιλα, βασεόφιλα, λεμφοκύτταρα και μονοκύτταρα.
Βλ.: εικόνα (σύσταση
του αίματος) και (τύποι κυτταρικών στοιχείων).
Ένας ενήλικος που ζυγίζει 70 κιλά έχει όγκο αίματος περίπου 5 λίτρα ή 70 ml ανά
κιλό βάρους. Το αίμα αποτελεί περίπου το 7%-8% του σωματικού βάρους. Το pH του κυμαίνεται μεταξύ 7,35 και 7,45, ενώ το ειδικό βάρος του ποικίλλει από
1.048 ως 1.066, με τα κύτταρα να είναι βαρύτερα και το πλάσμα ελαφρύτερο από αυτό. Το αίμα έχει ελαφρώς μεγαλύτερο ειδικό βάρος στους άνδρες από ότι
στις γυναίκες. Το ειδικό βάρος αυξάνει μετά από την σωματική άσκηση και κατά τη διάρκεια της νύχτας.
ΛΕΙΤΟΥΡΓΙΑ: Όταν το αίμα διέρχεται από
τους πνεύμονες αποβάλλει το διοξείδιο άνθρακα και προσλαμβάνει οξυγόνο. Όταν εξέλθει από την καρδιά μεταφέρεται στους ιστούς ως αρτηριακό αίμα και
επιστρέφει ξανά σε αυτήν διαμέσου του φλεβικού συστήματος. Στην αορτή κινείται με μια μέση ταχύτητα 30 cm/sec και διανύει το αγγειακό σύστημα σε 60
δευτερόλεπτα περίπου. Τα ερυθρά αιμοσφαίρια μεταφέρουν οξυγόνο. Τα λευκά αιμοσφαίρια συμμετέχουν στην ανοσολογική αντίδραση κατά των λοιμώξεων.
Τα αιμοπετάλια είναι σημαντικά στην πήξη του αίματος. Το πλάσμα μεταφέρει θρεπτικά συστατικά, άχρηστα προϊόντα, ορμόνες, διοξείδιο του άνθρακα και
άλλες ουσίες και συνεισφέρει στο ισοζύγιο ύδατος-ηλεκτρολυτών και στην ρύθμιση της θερμοκρασίας.
ΣΧΗΜΑΤΙΣΜΟΣ: Τα ερυθρά αιμοσφαίρια
παράγονται στον μυελό των οστών με ρυθμό 2.400.000/sec και καθένα από αυτά ζει περίπου 120 μέρες. Στα υγιή άτομα η συγκέντρωση των ερυθρών
αιμοσφαιρίων στο αίμα παραμένει σταθερή με το χρόνο. Τα αιμοπετάλια και τα λευκά αιμοσφαίρια παράγονται επίσης στον μυελό των οστών, ενώ τα λευκά
αιμοσφαίρια χωρίς κοκκία στον λεμφικό ιστό.
Υπώνυμος όρος
arteriolized blood
clotting of blood
cord
blood
defbrinated blood
formed elements of blood
occult blood
predonation of blood
sludged blood
unit of bloos